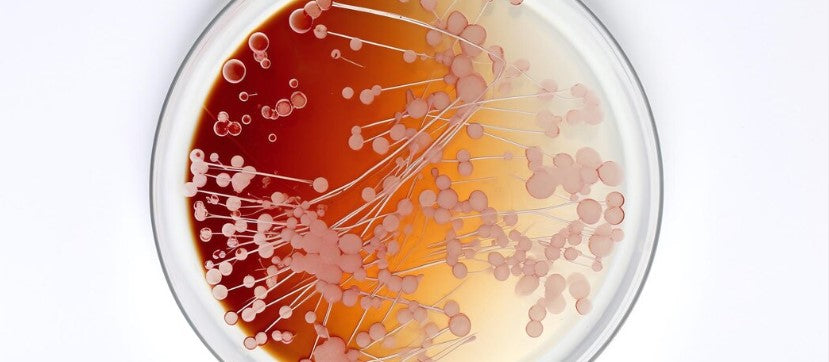

Mascarilla Coreana Nocturna de Colágeno Profundo PuraDerma™
Mascarilla Coreana Nocturna de Colágeno Profundo PuraDerma™
Hidratación Profunda
Aporta humedad intensa, revitalizando la piel seca y cansada.

Firmeza y Elasticidad
Reafirma la piel y mejora su elasticidad para un aspecto más joven.

Luminosidad Visible
Devuelve el brillo natural y un tono uniforme a tu piel desde las primeras aplicaciones.
No se pudo cargar la disponibilidad de retiro
Garantía De Devolución De Dinero Por 30 Días



-

— Carolina M. 37
"Sinceramente, esta mascarilla vale cada centavo. La mejor manera de describirla es que es como darle a mi piel un gran vaso de agua. La uso antes de eventos importantes y el maquillaje se aplica súper suave. ¡Me encanta!"
★★★★★
-

María G.
"Al principio era escéptica, pero después de solo una aplicación, mi piel se sintió tan suave y firme. Es perfecta para esas noches de autocuidado. Sin duda la recomiendo a quien busque ese brillo extra."
★★★★★
Garantía de devolución de dinero por 30 días
Garantía de devolución de dinero por 30 días
En PuraDerma confiamos en la calidad de nuestros productos y en los resultados visibles que ofrecen. Si después de 30 días de uso constante no notas ninguna mejoría, evaluaremos tu caso y, si corresponde, te ofreceremos un reembolso parcial o total.
Aviso importante: Los resultados pueden variar según el tipo de piel y la condición del contorno de ojos. En casos de bolsas o hinchazón más pronunciadas, puede ser necesario un uso más prolongado o combinar el tratamiento con otras soluciones complementarias, como terapia de luz roja o productos de apoyo específicos.
Nuestro objetivo es ayudarte a obtener los mejores resultados posibles — de forma segura, gradual y personalizada.
Modo de uso
Modo de uso
Después de limpiar la piel, retira las tiras adhesivas.
Aplica el parche en la zona deseada y presiona suavemente durante 5–10 segundos.
Usa 1–2 veces por semana durante al menos dos horas.
Para mejores resultados, déjalos actuar durante la noche.
Ingredientes
Ingredientes
Sodium Hyaluronate, Cafeína, Copper Tripeptide-1, Niacinamida, Ciclodextrina, Agua, Aceite de Glycine Soja, Madecassoside, Aceite de semilla de Macadamia Ternifolia, Alantoína, Retinol, Extracto de regaliz soluble en aceite, Extracto de Centella Asiática, Acetyl Hexapeptide-8, BHT.
Para obtener la información más actualizada, se recomienda revisar la lista de ingredientes impresa en el envase del producto antes de su uso o consumo.

































¿Sigues tirando dinero en “cremas milagrosas” para los ojos? Aquí va la verdad sobre los resultados - rápidos.
Hidratación profunda visible: El 97 % de los usuarios experimentaron una mayor hidratación y mejora en la textura de la piel desde el primer uso.
Menos arrugas, poros y líneas finas: Reducción visible e inmediata en el tamaño de los poros y líneas de expresión, revelando una piel más suave y uniforme.
Brillo juvenil con colágeno: Restaura la barrera de colágeno de la piel que se debilita con la edad, dejando la piel más radiante en solo minutos.

Resultados visibles desde las primeras aplicaciones
Notarás tu piel más firme, hidratada y luminosa desde la primera semana.

Efecto profesional, sin salir de casa
Sin procedimientos invasivos ni dolor solo resultados reales, desde la comodidad de tu hogar.
¿QUÉ DIFERENCIA HACEN 3 MASCARILLAS?


La Mascarilla Bio-Colágeno Puraderma™ Es Perfecta Para:
-

ARRUGAS
-

LÍNEAS DE EXPRESIÓN
-

PATAS DE GALLO
-

ACNÉ Y ROSÁCEA
Descubre la ciencia detrás del brillo
Nuestra fórmula exclusiva combina ingredientes potentes y clínicamente comprobados para transformar el contorno de tus ojos.Cada componente ha sido cuidadosamente seleccionado para brindar resultados visibles: una mirada más fresca, uniforme y luminosa.
-

Colágeno de bajo peso molecular
Penetra en las capas profundas de la piel, ayuda a reafirmar y reduce las arrugas.
-

Glicerina
Proporciona hidratación intensa y mejora la elasticidad de la piel
-

Ácido hialurónico
Mantiene altos niveles de hidratación, rellena líneas finas y deja la piel suave y luminosa.
-

Agua
Actúa como base natural de la fórmula y facilita la absorción de los ingredientes activos
-

Ácido cítrico
Equilibra el pH de la piel y contribuye a una apariencia más uniforme y luminosa
-

Agar
Crea una textura de gel natural y ayuda a calmar la piel
-

Citrato de potasio
Estabiliza la fórmula y contribuye al equilibrio del pH en la piel
Mascarilla de Colágeno PuraDerma – El Secreto para una Piel Radiante y Fresca
La innovadora mascarilla de colágeno de PuraDerma combina ingredientes premium como colágeno de bajo peso molecular, ácido hialurónico y niacinamida, que trabajan juntos para revitalizar la piel y aportar una hidratación profunda. Desde el primer uso, sentirás tu piel más suave, flexible y luminosa.
¿Qué la hace tan especial?
- Firmeza y elasticidad mejorada – El colágeno penetra en las capas profundas de la piel, reafirmando y proporcionando una sensación de tensión suave.
- Reducción de arrugas y líneas finas – La tecnología de ingredientes activos difumina los signos de la edad.
- Hidratación intensa – El ácido hialurónico mantiene la piel hidratada y evita la sequedad.
- Apariencia uniforme y saludable – La mascarilla aporta un brillo natural y un tono uniforme a la piel.
La mascarilla perfecta para un cuidado profesional en casa – Úsala una o dos veces por semana y verás cómo la apariencia de tu piel se transforma para siempre.

Por Qué Te Encantará
Efecto Piel de Cristal
Transforma la piel opaca en una tez radiante y luminosa.
Hidratación Profunda
Aporta hidratación intensa para una piel visiblemente más rellena y suave.
Transformación de la Textura
Refina la textura de la piel, dejándola suave y sin poros.
Brillo Instantáneo
Aporta luminosidad inmediata y un acabado perfecto para la cámara.
Poder Antienvejecimiento
Deja la piel radiante y luminosa durante días.
¿Por Qué La Máscara De Colágeno PuraDerma™ Supera a Cualquier Crema?
¿Harta de probar cremas sin ver resultados reales?
Así es como las que saben ya hicieron el cambio inteligente:

|
Crema |
Acción Profunda de Colágeno |
|---|---|---|
4 Veces Más Hidratación |
||
Resultados Visibles y Rápidos |
||
Aplicación Precisa y Sin Desperdicio |
||
Comprobado Clínicamente y Recomendado |
FAQs
¿Tienes preguntas?
¿Cada cuánto debo usar la mascarilla?
Recomendamos usarla entre 1 y 2 veces por semana para obtener los mejores resultados.
¿Cuántas mascarillas vienen en un paquete?
Cada paquete incluye 4 mascarillas de colágeno listas para usar.
¿Debo dejar la mascarilla toda la noche?
Sí, se recomienda dejarla actuar durante toda la noche. Aun así, el sérum puede absorberse completamente en unas 4 horas.
¿Es segura para todo tipo de piel?
Sí. La fórmula no contiene químicos agresivos ni parabenos, y no ha sido probada en animales.
¿La mascarilla ayuda con arrugas y líneas finas?
¡Sí! El 88% de las usuarias reportaron una reducción visible de líneas finas y una piel más firme.
¿Puedo usarla durante el día?
Sí, aunque está diseñada para la noche, también puedes usarla durante el día si dejas que el sérum se absorba completamente.